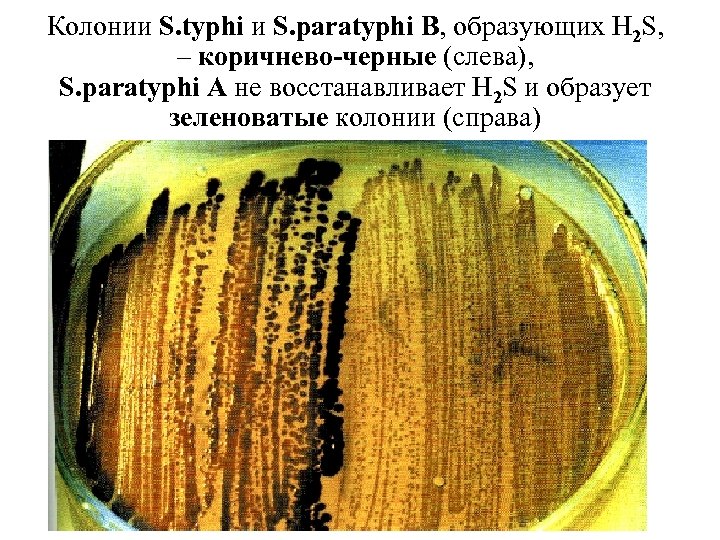
Колонии S. typhi и S. paratyphi B, образующих H 2 S, – коричнево-черные (слева),
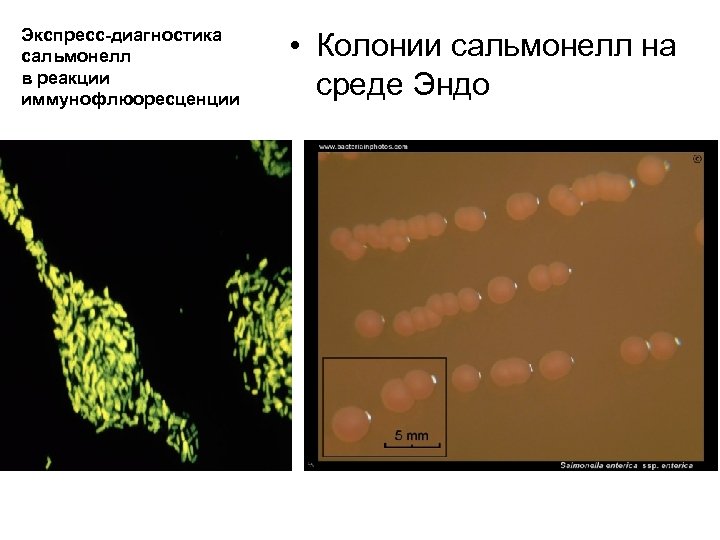
Экспресс-диагностика сальмонелл в реакции иммунофлюоресценции • Колонии сальмонелл на среде Эндо
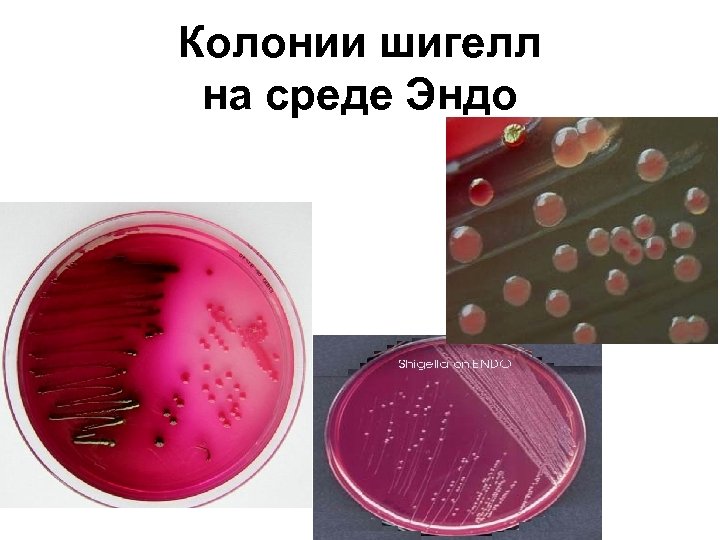
Колонии шигелл на среде Эндо
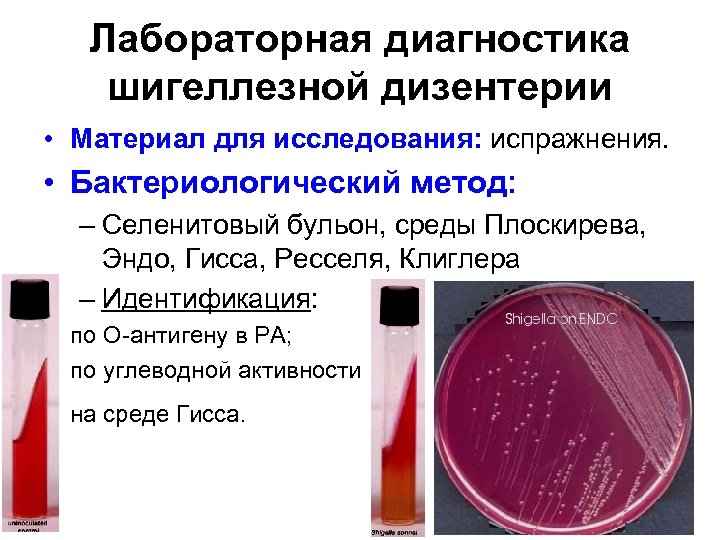
Лабораторная диагностика шигеллезной дизентерии • Материал для исследования: испражнения. • Бактериологический метод: – Селенитовый

58af6106da81ca0d1e249e91e2850625.ppt
- Количество слайдов: 88

Лекцию читает: Заведующий кафедрой микробиологии, вирусологии и иммунологии доктор медицинских наук, профессор Минухин Валерий Владимирович

ТЕМА ЛЕКЦИИ:

К ВНИМАНИЮ СТУДЕНТОВ! • На кафедре микробиологии, вирусологии и иммунологии имеется почтовый электронный адрес – • present. mikro 1922@ukr. net • Написав на этот адрес запрос Вы можете бесплатно получить презентацию этой лекции. • С ув. проф. В. В. Минухин.

П Л А Н Л Е К Ц И И: • 1. Общая характеристика и классификация энтеробактерий. • 2. Эшерихии. Классификация. Биологические свойства. Методы лабораторной диагностики. Лечение и профилактика. • 3. Сальмонеллы. Классификация. Биологические свойства. Методы лабораторной диагностики. Лечение и профилактика. • 4. Шигеллы. Классификация. Биологические свойства. Методы лабораторной диагностики. Лечение и профилактика.

Энтеробактерии (лат. Enterobacteriaceae) — • Большое семейство бактерий, включающее в себя 35 родов, в т. ч. такие известные патогены как: кишечная палочка, сальмонелла, шигеллы, чумная палочка и др. • По форме — бациллы (палочкообразные) длиной 1— 5 мкм. Как и другие протеобактерии, они грамотрицательны.

Enterobacteriaceae

Энтеробактерии — • растут на простых питательных средах, особенно хорошо растут на средах с добавлением мясного экстракта.

Энтеробактерии — • факультативные анаэробы и ферментируют углеводы с образованием муравьиной кислоты и других конечных продуктов (так называемое формиатное брожение). Некоторые энтеробактерии могут разлагать лактозу. • Большинство имеет жгутики для передвижения. Иногда фимбрии. • Не образуют спор.

Основные роды семейства: • • Escherichia Salmonella Shigella Proteus Klebsiella Yersinia Enterobacter Erwinia и другие.

Антигенное строение энтеробактерий • Отличают 3 основных типа антигенов: • 1. О-соматический антиген (АГ); • 2. Н-жгутиковый АГ; • 3. К-капсульный АГ.

Патогенное действие обусловлено: • 1. Белками клеточной мембраны, капсульным полисахаридом, ворсинками, токсинами. • 2. Вирулентность – повышенной адгезией, положительным хемотаксисом между поверхностными структурами м/о и рецепторами эпителия. • 3. Имеют эндотоксин и экзотоксин (энтеротоксин, цитотоксин).

Кишечная палочка – Escherichia coli • - была описана немецким педиатром и бактериологом Теодором Эшерихом в 1885 году. • В настоящее время кишечную палочку относят к роду Escherichia, семейству Enterobacteriaceae, порядку Enterobacteriales.

МОРФОЛОГИЯ: • E. coli — грамотрицательная бактерия, факультативный анаэроб, не образует эндоспор. • Клетки палочковидные, со слегка закруглёнными концами, размером 0, 4 — 0, 6 х 2— 6 мкм, объём клетки составляет около 0, 6— 0, 7 μm. • Имеет перитрихиально расположенные жгутики.

Escherichia coli (Гр. - )

Escherichia coli

Низкотемпературная электронная микрофотография кластера E. coli. Увеличение в 10 000 раз.

Кишечная палочка может жить на разных субстратах. • В анаэробных условиях E. coli образует в качестве продукта жизнедеятельности лактат, сукцинат, этанол, ацетат и углекислый газ. • При этом образуется молекулярный водород, который мешает образованию указанных выше метаболитов, поэтому E. coli часто сосуществует с микроорганизмами, потребляющими водород.

Рост E. coli на МПА и МПБ • На плотных средах: – выпуклые полупрозрачные S-колонии с ровными или слегка вол нистыми краями (3 -5 мм в диаметре) – сухие плоские R-колонии с неровными краями. • В жидких средах: – диффузное помутнение среды и образование осадка.

Оптимальный рост достигается • при температуре 37 °C, некоторые штаммы могут делиться при температурах до 49 °C. Рост может стимулироваться аэробными или анаэробным дыханием, различными парами окислителей и восстановителей, в том числе, окислением пирувата, формиата, водорода.

• Факультативные анаэробы, t оптимум 37°С. • Ферментируют углеводы до кислоты или кислоты и газа. • Оксидаза-отрицательны. • Каталаза-положительны. • Продукция индола.

УСТОЙЧИВОСТЬ ВО ВНЕШНЕЙ СРЕДЕ • Довольно устойчивы в окружающей среде (например, на загрязненных поверхностях пеленальных столов, игрушках могут сохраняться более 100 дней); • при кипячении гибнут в течение 15 с, под действием 1% р-ра хлорамина или 5% р-ра лизола - в течение 3 - 5 мин.

• Штаммы, имеющие жгутики, способны передвигаться. Жгутики расположены перитрихально. На конце жгутика расположен белок Fim. H, который прикрепляется к молекулам сахаров на поверхности, • эпителия • кишечника.

E. coli в норме заселяет кишечник новорождённого ребенка в течение первых 40 часов • после рождения, поступая с пищей или от лиц, контактирующих с ребёнком, и сохраняются на протяжении жизни на уровне 106— 108 КОЕ/г содержимого толстой кишки.

• В ЖКТ кишечные палочки прилипают к слизистым оболочкам и являются основными представителями факультативных анаэробов у человека. • Так кишечные палочки не имеют бактериофагов, кодирующих факторы вирулетности, они являются комменсалами.

Коли-инфекция (син. эшерихиоз) • - группа инфекционных болезней, вызываемых патогенными серотипами кишечных палочек.

• Наиболее часто эти бактерии вызывают острые кишечные расстройства (кишечную коли-инфекцию), а у детей раннего возраста и у ослабленных лиц могут также явиться причиной поражения мочевыводящих путей (пиелонефрит, цистит), иногда – развития холецистита, менингита, сепсиса.

Источниками патогенных кишечных палочек являются больной коли-инфекцией, бактерионоситель, а также инфицированные молодые домашние животные (телята, поросята и др. ). Пути заражения - пищевой, водный, у детей раннего возраста (особенно новорожденных), кроме того, и контактно-бытовой (возбудитель инфекции передается через загрязненные руки матерей, обслуживающего персонала, через предметы ухода за ребенком и др. ).

Клиническая картина • У детей раннего возраста, особенно первых месяцев жизни, коли-инфекция начинается, как правило, постепенно. Отмечаются снижение аппетита, срыгивания, остановка прибавки массы тела, некоторое учащение и разжижение стула. К 5 -7 -му дню присоединяются лихорадка (чаще умеренная), рвота, стул учащается до 10 и более раз в сутки, испражнения становятся водянистыми.

Различают 5 основных групп патогенных эшерихий: • энтеропатогенные — вызывают диарею у детей, патогенез обусловлен способностью бактерии прикрепляться к эпителию кишечника и повреждать микроворсинки; • энтероинвазивные — вызывают воспаление слизистой оболочки толстой кишки, по своим свойствам сходны с шигеллами; • энтеротоксигенные — вызывают холероподобную диарею; продуцируют устойчивый энтеротоксин, сходный по структуре с холерным; • энтерогеморрагические — вызывают гемморагическую диарею; образуют цитотоксин, аналогичный дизентерийному токсину; • энтероадгезивная - нарушает всасывание, прикрепляясь к слизистой и выстилая просвет.

Поражение Серогруппы О-антиген Н-антиген Кишечника Энтеротоксигенные (ЭТКП) 06, 08, 011, 015, 020, 025, 027, 063, Н 4, Н 7, Н 9, Н 11, 078, 080, 085, 0114, 0115, Н 12, Н 19, 0126, 0128, 0139, 0148, 0153, Н 20, Н 21, 0159, 0166, 0167 Н 28, Н 40 Энтеропатогенные (ЭПКП) 018, 026, 044, 055, 086, 0111, 0112, Н 2, Н 6, Н 7, Н 11, 0114, 0119, 0125, 0127, 0128 Н 12, Н 14 Энтероинвазивные (ЭИКП) 028, 029, 0112, 0115, 0124, 0135, 0136, 0143, 0144, 0152, 0164, 0167 Энтерогеморагические (ЭГКП) 026, 0157 Энтероагрегирующие (ЭАКП) 03, 015, 044, 077, 086, 0127 Мочевыводящие пути 01, 02, 04, 06, 07, 08, 09, 011, 018, 022, 025, 062, 075 К 1, К 2, К 5, К 12, К 13 Бактериемия 01, 02, 04, 06, 07, 08, 09, 011, 018, 022, 025, 075 К 1, К 2, К 5, К 12, К 15, К 23 Менингиты 01, 06, 07, 016, 018, 083 К 1 Н 6, Н 7, Н 8, Н 11

Диареегенные эшерихии

Энтеротоксигенные кишечные палочки (ЭТКП) • Нецитотоксичные, неинвазивные. • Действие энтеротоксина: нарушение водносолевого баланса и обильная диарея «секреторного» типа. - Диарея путешественников. - Холероподобная диарея.

Энтеропатогенные кишечные палочки (ЭПКП) - О 26, О 55, О 111 • Диарея у детей 1 -го года жизни. • Патогенез: адгезия бактерий на эпителии тонкого кишечника и повреждение • микроворсинок, • сглаживание • слизистой, м. б. • эрозии, бактериемия.

Энтероагрегирующие кишечные палочки (ЭАКП) • Диарея у детей. • Агрегативное прикрепление – препятствие абсорбции жидкости – обезвоживание.

Энтероинвазивные кишечные палочки (ЭИКП) • Дизентериеподобные заболевания. • Цитотоксичные: – – – – – Размножаются в эпителиоцитах толстой кишки. Разрушение эпителиоцитов, воспаление и изъязвление слизистой. • Возможна диарея • «инвазивного» типа.

Энтерогеморрагические кишечные палочки (ЭГКП) О 157: Н 7 и )26: Н 11 • Геморрагическая диарея (геморрагический колит). • Гемолитический уремический синдром. • Патогенез: цитотоксин и • шигаподобные • токсины • вызывают • гибель клеток.

Лабораторная диагностика эшерихиозов • Материал для исследования: – – – испражнения, рвотные массы, дуоденальное содержимое, кровь, моча, гной, спинномозговая жидкость, от трупов - кровь из сердца, содержимое кишечника, кусочки легких, печени, селезенки, почек. – При необходимости исследуют промывные воды желудка, остатки пищи, смывы из рук.

МЕТОДЫ: • Бактериологический. • Идентификация: – по О-антигену в РА; – по углеводной активности на среде Гисса. • Бактериоскопический: обнаружение бактерий в крови, ликворе, раневом отделяемом. • РИФ: обнаружение антигена. • Серологический: ИФА для обнаружения LT- и ST-энтеротоксинов. • ПЦР: обнаружение генов, кодирующих факторы вирулентности.

Определение E. coli в реакции иммунофлюоресценции

Автоматизированный биохимический тест • Позволяет определить 20 показателей биохимическо й активности бактерий.

Серодиагностика E. coli в реакции агглютинации на стекле Отрицательная Положительная

Сальмонеллез ‑ острая инфекционная болезнь, вызываемая бактериями рода Salmonella, • попадающими в организм человека с пищевыми продуктами животного происхождения. • Открыты в 1885 году американским микробиологом Даниелем Сальмоном. • Патогенные серовары сальмонелл: S. Enteritidis (dublin) S. Choleraesuis S. Typnimurium

Сальмонеллы • Грам-отрицательные, подвижные палочки, спор и капсул не образуют. • Факультативные анаэробы. • Лактозо-отрицательные. • Образуют H 2 S.

Сальмонеллы

S a l m o n e l l a
Колонии S. typhi и S. paratyphi B, образующих H 2 S, – коричнево-черные (слева), S. paratyphi A не восстанавливает H 2 S и образует зеленоватые колонии (справа)

Рост сальмонелл на висмут-сульфит агаре

Классификация рода Salmonella • Виды: • Salmonella enterica – 6 подвидов, более 2500 сероваров. • Salmonella bongori – 10 сероваров, редко встречаются.

Классификация рода Salmonella enterica subs. еnterica • Сальмонеллы тифопаратифозной группы: – Salmonella Typhi – Salmonella Paratyphi A – Salmonella Schottmuelleri • Сальмонеллы – возбудители сальмонеллезов (сальмонеллезных гастроэнтеритов): – – Salmonella Typhimurium Salmonella Enteritidis Salmonella Choleraesuis и другие (более 2500).

Рост S. typhi на средах Гисса

Серологические свойства • О-антиген (более 60 групп) • Н-антиген (специфические и неспецифические фазы) • Vi-антиген (S. Typhi) ____________ Для серологической идентификации сальмонелл используют схему Кауфмана-Уайта.

Серологическая классификация рода Salmonella

Факторы вирулентности сальмонелл: • Устойчивость к действию желудочного сока и кислым значениям р. Н фагосом. • Факторы колонизации: адгезия к эпителию кишечника. • Инвазин – белок наружной мембраны: проникновение в клетки эпителия и макрофаги. • Фермент супероксиддисмутаза: резистентность к фагоцитозу. • Факторы резистентности к бактерицидному действию сыворотки. • Эндотоксин: развитие лихорадки. • Энтеротоксин: повышение секреции жидкости.

Резистентность • в воде открытых водоёмов и питьевой воде — 11 -120 сут, • в морской воде — 15 -27 сут, • в почве — 1 -9 мес, • в комнатной пыли — 80 -547 сут, • в колбасных изделиях — 60 -130 сут, • в замороженном мясе — 6 -13 мес, • в яйцах — до 13 мес, • на замороженных овощах и фруктах — 0, 5 -2, 5 мес. • Кипячение убивает сальмонелл мгновенно. • 0, 3% р-р хлорной извести — 1 ч. • Хлорирование сточных вод снижает их загрязнённость сальмонеллами в 6 раз.

Брюшной тиф – острая системная антропонозная инфекция, которая характеризуется – поражением лимфатического аппарата тонкой кишки, – бактериемией, – интоксикацией, – розеолезной сыпью, – увеличением печени и селезенки.

Брюшной тиф и паратифы • Источник инфекции – человек (больной, бактерионоситель). • Механизм передачи: – фекально-оральный. • Путь передачи: – водный, – алиментарный, – контактно-бытовой.

Патогенез сальмонеллезной инфекции Приводит к развитию воспаления с преимущественным поражением лимфоидной ткани и вторичными дефектами энтероцитов. При продукции энтеротоксинов развивается диарея.

Патогенез брюшного тифа

Патогенез брюшного тифа • Сальмонелла • Тонкий кишечник • Размножение в лимфатических образованиях • Бактериемия • Паренхиматозные органы • Бактериемия, интоксикация • Желчный пузырь • Тонкий кишечник • Аллергическая реакция в пейеровых бляшках • Воспаление, некроз • Прободение кишечника

Клиника • • • Лихорадка (39 -40 град. С). Интоксикация. Гепатоспленомегалия, сыпь. Бред, галлюцинации. Нарушение ССС (гипотония, коллапс).

Рис. 1. Лимфатические узлы илеоцекального угла брыжейки. Рис. 2. Некроз пейеровых бляшек. Рис. 3. Язык больного брюшным тифом. Рис. 4 -5. Сыпь.

Сальмонеллезные гастроэнтериты Источник инфекции: животные, птицы, люди (больные и бактерионосит ели). Механизм передачи: фекальнооральный. Путь передачи: алиментарный, водный, контактный.

Проникновение сальмонелл

Патогенез сальмонеллёза • Salmonella • Тонкий кишечник • Острое воспаление • Эндотоксин, энтеротоксин • Активация аденилатциклазы, повышение уровня ц. АМФ • Обильная секреция жидкости • Диарея

КЛИНИКА САЛЬМОНЕЛЛЕЗА • Гастроинтестинальная форма – острое начало, выраженная интоксикация (высокая t, головная боль, слабость, озноб, миалгия), тошнота, рвота, боли в животе, понос (кал обильный, зловонный, в виде “болотной тины” или “лягушачьей икры”), возможны разные степени дегидратации (І-ІV) • Генерализованная форма: – тифоподобный вариант – острое начало, озноб, повышение температуры тела, явления гастроэнтерита, гепатоспленомегалия, вздутие живота, высыпания – септико-пиемический вариант – клиника сепсиса (септический эндокардит, холецистохолангит, гломерулонефрит, гнойный менингит) • Бактериемия: гнойные процессы в костях, суставах, оболочках мозга, плевре и др. тканях. • Бактерионосительство – транзиторное, острое, хроническое.

Лабораторная диагностика сальмонеллеза • Материал для исследования: – испражнения, моча, желчь, промывные воды желудка, кровь, продукты. • РИФ. • Бактериологический метод: – среды: • желчный и селенитовый бульон, • висмут-сульфит агар, Плоскирева, Эндо. – Идентификация: по О-антигену в РА; по углеводной активности на среде Гисса. • Серологический метод: – ИФА и РПГА.
Экспресс-диагностика сальмонелл в реакции иммунофлюоресценции • Колонии сальмонелл на среде Эндо

Иммунитет • Напряженный, длительный. • Антитела к: – О-антигену – с конца 1 -ой недели. – Н-антигену – период реконвалесценции, после вакцинации. – Vi-антигену – у бактерионосителей.

Лабораторная диагностика брюшного тифа • Материал для исследования: – кровь – 1 -ая неделя, – испражнения, моча, желчь – с конца 2 -ой недели. • Бактериологический метод: – среды: • желчный и селенитовый бульон, • висмут-сульфит агар, Плоскирева, Эндо. – Идентификация: по О-антигену в РА; по углеводной активности на среде Гисса. • РИФ – определение антигена. • Серологический метод: – ИФА. – РПГА с О-, Н-, Vi-антигенами (титр 1: 200).

Специфическая профилактика брюшного тифа • Химическая вакцина TABte. • Спиртовая брюшнотифозная вакцина, обогащенная Viантигеном. • Брюшнотифозный бактериофаг (экстренная профилактика).

ШИГЕЛЛЫ – ВОЗБУДИТЕЛИ БАКТЕРИАЛЬНОЙ ДИЗЕНТЕРИИ

Шигеллы представляют собой • Грам-отрицательные, неподвижные палочки, спор и капсул не образуют. • Факультативные анаэробы, лактозоотрицательные, не образуют H 2 S. • Заболевание - бактериальная дизентерия (шигеллез).

Чистая культура шигелл (окр. По Граму)

Шигелла


Биохимические свойства рода Shigella

ПОСЕВ НА СРЕДУ ПЛОСКИРЕВА • дифференциально-диагностическая и селективная среда. • Содержит: – – – питательный агар, лактоза, бриллиантовый зеленый, соли желчных кислот, индикатор (нейтральный красный
Колонии шигелл на среде Эндо

Среда Клиглера • Содержит: – – – глюкозу, лактозу, тиосульфат натрия, сульфат железа, индикатор фенол рот. • При ферментации только • глюкозы – желтый столбик. • При ферментации и глюкозы, и лактозы (E. coli) – весь агар желтый. • При образовании сероводорода (сальмонеллы) – агар чернеет.

Факторы вирулентности шигелл • Адгезия и колонизация: – – фимбрии, белки наружной мембраны липополисахарид, нейраминидаза, гиалуронидаза, муциназа. • Шига-токсин (S. dysenteriae 1 серовар): – цитотоксин (поражение эндотелия подслизистой кишечника и гломерул почек), – энтеротоксин (нарушение водно-солевого баланса), – нейротоксин (нарушение деятельности ЦНС). • Шигаподобные токсины (остальные

Бактериальная дизентерия • Источник инфекции – человек. • Механизм передачи: – фекально-оральный. • Пути передачи: – Алиментарный (пищевой); – Водный; – Контактно-бытовой.

Патогенез дизентерии

Shigella инвазирует эпителиальные клетки (сканирующая электронная микроскопия)

КЛИНИКА ШИГЕЛЛЕЗА: • Инкубационный период – от 3 час до 7 суток. • Начало болезни острое, с озноба, лихорадки, явлений интоксикации, болей в животе, поноса. • Боль схваткообразная, тенезмы. • Испражнения с примесью слизи, гноя и крови, иногда теряют каловый характер (“ректальный плевок”). И М М У Н И Т Е Т : • Нестойкий • ненапряженный • типоспецифический
Лабораторная диагностика шигеллезной дизентерии • Материал для исследования: испражнения. • Бактериологический метод: – Селенитовый бульон, среды Плоскирева, Эндо, Гисса, Ресселя, Клиглера – Идентификация: • по О-антигену в РА; • по углеводной активности на среде Гисса.

Патогенетическое лечение бактериальных кишечных инфекций • 1. Антибиотики: – пенициллины (амоксициллин), – цефалоспорины 3 -го поколения (цефотаксим, цефтриаксон и др. ), – аминогликозиды (гентамицин, канамицин), – тетрациклины. • 2. Лечебные фаги: – коли-протейный, – колифаг, – интести-фаг, – сальмонеллезный, – дизентерийный. • 3. Препараты для коррекции микрофлоры кишечника: – бифидумбактерин форте, – пробиформ, – бифиформ и др.

Интести-бактериофаг • иммунобиологический препарат с антимикробными свойствами, фаг. • Интести-бактериофаг обладает способностью специфически лизировать: – – – – – S. flexneri I, III, IV и VI типов S. sonnei, S. paratyphi A, S. paratyphi В, S. typhimurium, S. infantis, S. cholerasuis, S. oranienburg, S. enteritidis; Escherichia coli, Proteus vulgaris и mirabilis, Enterococcus, Staphylococcus, Pseudomonas aeraginosa.

Профилактика кишечных инфекций
58af6106da81ca0d1e249e91e2850625.ppt